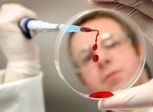

За рубежом 

С 2014 года Великобритания планирует свернуть свою кооперацию с Европейским союзом в области юстиции и внутренней политики.
-
 Япония находится в худшем положении, чем Греция 18.10.2012
Япония находится в худшем положении, чем Греция 18.10.2012
К концу года государственный долг Японии может достичь 237% ВВП. Такие неутешительные прогнозы дают эксперты Международного валютного фонда, пишет The Wall Street Journal.
-
 Половина шведских пилотов спят за штурвалом 15.10.2012
Половина шведских пилотов спят за штурвалом 15.10.2012
У половины пилотов шведских авиалиний были случаи, когда они засыпали прямо во время полета. Об этом сообщает "Интерфакс-Украина" со ссылкой на францускую газету "Монд".
-
В Германию вместе с замороженой клубникой из Китая попала кишечная инфекция . 15.10.2012
В Германию вместе с замороженой клубникой из Китая попала кишечная инфекция . 15.10.2012
Возбудителями вспышки кишечной инфекции, от которой пострадали более 11 тыс. человек, являются так называемые норовирусы, которые были в замороженной клубнике из Китая.
-
 Украинская диаспора в России сократилась на 1 млн. человек 12.10.2012
Украинская диаспора в России сократилась на 1 млн. человек 12.10.2012
С 2001 по 2011 год количество украинцев в России сократилось на 1 млн человек. Такие результаты переписи населения в интервью Радио "Свобода" прокомментировал Чрезвычайный и полномочный посол Украины в Российской Федерации Владимир Ельченко.
-
 Чемпион мира по боксу нокаутировал шестерых угонщиков автомобилей 10.10.2012
Чемпион мира по боксу нокаутировал шестерых угонщиков автомобилей 10.10.2012
В Британии у экс-чемпиона мира по боксу в лёгкой весовой категории Амира Хана 6 грабителей попытались угнать автомобиль.
Архитектура
Дизайн интерьеров
Стройматериалы
Парки мира
Мариинский парк
За годы своего существования в Мариинском парке были высажены разнообразные декоративные деревья и кустарники.Аллеи парка – извилистые и нарочито естественно вписанные в ландшафт – досихпор украшают клены, липы и каштаны.
Ливадийский парк
Это красивый ландшафтный парк с элементами регулярного, тип итальянских террасных садов, к которому на склонах примыкает естественный крымский лес он был любимым садом императрицы Марии Романовой. Здесь специально для нее по всему парку были высажены хвойники для лечения ее больных легких Расстояние от Ялты – 3 км, от Киева – 1060 км. Расположен в Ливадии.
Аскания-Нова
Асканийский заповедник отнесен к «100 великим заповедникам и паркам мира» здесь расположен единственный в Европе участок типчако-ковыльной степи, которого никогда не касался плуг!
Усадьба Ла Гранха - удивительный ландшафт
Небольшой остров Майорка размерами 70х100 километров расположен в Средиземноморье. Он необыкновенно красив и разнообразен. С благоприятным, мягким климатом и сказочными пейзажами. Это самый крупный остров Балеарского архипелага, территория которого буквально усеяна природными национальными парками. Из всех регионов Испании, Майорка обладает самым высоким уровнем жизни.
Парки Майорки, Усадьба Ла Гранха - удивительный парк который вас удевит своей красотой. Озеро Синевир
Озеро СиневирСтоит посмотреть, потому что:
- это самое большое горное озеро Карпат
- здесь расположен уникальный Музей леса и сплава, которому в Европе нет аналогов
- здесь произрастают 52 растения, занесенных в Красную книгу, и даже есть представители, характерные для флоры тундры и тайги






















